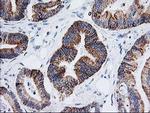
Adenylate Kinase 4 Antibody in Immunohistochemistry (Paraffin) (IHC (P))

Search
Invitrogen
Adenylate Kinase 4 Monoclonal Antibody (OTI3B1)
{{$productOrderCtrl.translations['antibody.pdp.commerceCard.promotion.promotions']}}
{{$productOrderCtrl.translations['antibody.pdp.commerceCard.promotion.viewpromo']}}
{{$productOrderCtrl.translations['antibody.pdp.commerceCard.promotion.promocode']}}: {{promo.promoCode}} {{promo.promoTitle}} {{promo.promoDescription}}. {{$productOrderCtrl.translations['antibody.pdp.commerceCard.promotion.learnmore']}}

Please note: We are reviewing Western blot images included in the antibody testing data in our catalog, including those provided by third parties. Unless expressly labeled or annotated as “raw-unedited”, Western blot images included in the antibody testing data in our catalog may have been edited, optimized or otherwise adjusted for presentation.
产品信息
MA5-25568
种属反应
宿主/亚型
分类
类型
克隆号
抗原
偶联物
形式
浓度
规格
纯化类型
保存液
内含物
保存条件
运输条件
RRID
靶标信息
This gene encodes a member of the adenylate kinase family of enzymes. The encoded protein is localized to the mitochondrial matrix. Adenylate kinases regulate the adenine and guanine nucleotide compositions within a cell by catalyzing the reversible transfer of phosphate group among these nucleotides. Five isozymes of adenylate kinase have been identified in vertebrates. Expression of these isozymes is tissue-specific and developmentally regulated. A pseudogene for this gene has been located on chromosome 17. Three transcript variants encoding the same protein have been identified for this gene. Sequence alignment suggests that the gene defined by NM_013410, NM_203464, and NM_001005353 is located on chromosome 1.
仅用于科研。不用于诊断过程。未经明确授权不得转售。
篇参考文献 (0)
生物信息学
蛋白别名: adenylate kinase 3 alpha-like 1; Adenylate kinase 3-like; adenylate kinase 3-like 1; adenylate kinase 3-like 2; adenylate kinase 3-like {ECO:0000255|HAMAP-Rule:MF_03170}; Adenylate kinase 4, mitochondrial; adenylate kinase 4, mitochondrial {ECO:0000255|HAMAP-Rule:MF_03170}; adenylate kinase isoenzyme 4, mitochondrial; AK 4; AK 4 {ECO:0000255|HAMAP-Rule:MF_03170}; ATP-AMP transphosphorylase; GTP:AMP phosphotransferase AK4; GTP:AMP phosphotransferase AK4 {ECO:0000255|HAMAP-Rule:MF_03170}; GTP:AMP phosphotransferase AK4, mitochondrial; RP4-686B20.1
基因别名: AK 4; Ak-3; Ak-4; AK3; Ak3b; AK3L1; Ak3l2; AK4; D4Ertd274e
UniProt ID: (Rat) Q9WUS0, (Mouse) Q9WUR9
Entrez Gene ID: (Dog) 489554, (Rat) 29223, (Mouse) 11639




